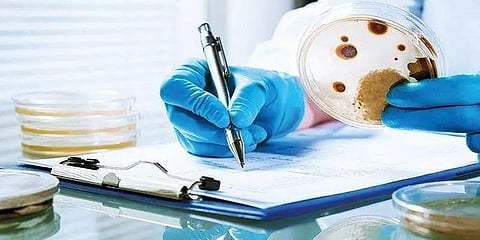
கருப்பு பூஞ்சை மருந்து வாங்க தமிழ்நாடு அரசு ரூ.25 கோடி ஒதுக்கீடு

தமிழ்நாடு
கருப்பு பூஞ்சை மருந்து வாங்க தமிழ்நாடு அரசு ரூ.25 கோடி ஒதுக்கீடு
கருப்பு பூஞ்சை மருந்து வாங்க தமிழ்நாடு அரசு ரூ.25 கோடி ஒதுக்கீடு
கருப்பு பூஞ்சைக்கான மருந்துகளை வாங்க முதல்வரின் பொது நிவாரண நிதியிலிருந்து ரூ.25 கோடி நிதி ஒதுக்கீடு செய்யப்பட்டுள்ளது.
முதலமைச்சரின் கொரோனா நிவாரண நிதிக்கு அரசு, சினிமா பிரபலங்கள் உட்பட பொதுமக்கள் பலரும் தங்கள் நிதிகளை தொடர்ந்து அளித்துவருகின்றனர். கொரோனா நிவாரண நிதியாக இதுவரை ரூ.280.20 கோடி நன்கொடையாக பெறப்பட்டுள்ளதாக தமிழக அரசு கூறியுள்ளது. ஏற்கெனவே சிங்கப்பூர் மற்றும் பிற நாடுகளிலிருந்து ஆக்சிஜன் உருளைகள், கொரோனா சிகிச்சை மருந்துகள் மற்றும் ஆக்சிஜன் செறிவூட்டிகளுக்கு ரூ.41.40 கோடி நிதி ஒதுக்கீடு செய்யப்பட்டது.
இந்நிலையில், பொது நிவாரண நிதியிலிருந்து கருப்பு பூஞ்சை நோய்க்கு மருந்துவாங்க ரூ.25 கோடி ஒதுக்கீடு செய்யப்படுவதாக அறிவித்துள்ளது.